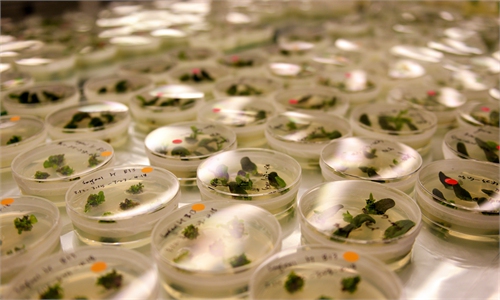

Syngenta Group
Syngenta Group, the agriculture giant owned by China National Chemical Corp, has applied for an IPO in the STAR Market in Shanghai where it aims to raise 65 billion yuan ($10 billion). This would be the largest IPO in China's A-share markets since that of Agricultural Bank of China in 2010.
Industry insiders said that the IPO could help boost the company's business and China's influence in the global agricultural sector that has long been dominated by several Western giants and create healthier competition in the industry.
The IPO, which comes as China has been stepping up development in seeds and other critical areas to cut foreign reliance, may make the company a leading global player, experts noted.
Syngenta ranked third in the global seed industry in 2020 with a market share of 7 percent, behind Germany's Bayer with 20 percent and the US' Corteva with 17 percent, according to Kynetec, a global animal health and agriculture researcher, news site chinastarmarket.cn reported on Saturday.
"The listing of Syngenta may have a great impact on the global agricultural industry, as the company will have more capital to focus on advanced agricultural technology research and overseas acquisitions, among other issues," Ma Wenfeng, a senior analyst at the Beijing Orient Agribusiness Consultancy, told the Global Times on Sunday.
The estimated market value of Syngenta is over 300 billion yuan, the largest on the STAR market. The IPO application was accepted by the Shanghai Stock Exchange on Friday, media reports said.
Jiao Shanwei, editor-in-chief of cngrain.com, a website specializing in grain news, told the Global Times on Sunday the listing will channel capital into the nation's agricultural priorities. It will speed up research and development, especially in some bottleneck sectors such as seed cultivation, Jiao said.
Domestic seeds occupy a dominant position for some grain crops, but in the field of feed, such as corn, the seeds have been monopolized by foreign companies for a long time, analysts said.
In June 2017, ChemChina completed the acquisition of Syngenta, the largest overseas acquisition by a Chinese company to date.
Industry insiders said that the listing will strengthen Syngenta's competitive position in the sector and may break the long-term Western monopoly.
"Its listing will enhance China's voice in the world and prevent the global industry from being monopolized by a few enterprises from Western countries," said Jiao.
Syngenta did not respond to a Global Times' request for comment as of press time on Sunday.
The company is part of a sunrise industry in China's strategic development. For example, the market for vegetable seeds is expected to double by 2030, media reports said.
With the development and commercialization of breeding technology, corn and other feed crop seeds also have huge commercial value in China, experts said.
Syngenta ranks first in China's plant protection industry and second in the seed industry.
The IPO proceeds will help China introduce advanced seed technologies to improve domestic grain production. Soybean and corn yields in South America are about two times those of China, while the yield of wheat in Europe is about one and a half times that of China, said Ma.
The global precision agriculture market is expected to exceed $4 billion by 2025, and the company has proven advantages in the field. The revenue generated by Modern Agriculture Platform, Syngenta's digital agricultural services platform in China, tripled to $700 million in 2020 and further rapid growth is expected, the China Securities Journal reported on Friday.
Industry insiders said that China's capital market will welcome a truly world-class agricultural technology giant.
Syngenta ranked No.1 in the global plant protection industry, No.3 in the seed industry and No.1 in the digital service area in 2019, with a leading position in the field of digital agriculture, public data showed.
ChemChina's acquisition of Syngenta in 2017 was controversial because of its high debt, sluggish global market growth and uncertain prospects for business integration.
However, within just four years, Syngenta's operating income was first in the world for two consecutive years.
Syngenta has significantly reduced its operating risks through debt optimization, especially after the completion of debt restructuring in 2020. Its asset-liability ratio fell to 40.51 percent, lower than the average level of comparable listed companies, in stark contrast with 57.2 percent at the end of 2019 and 56.3 percent in late 2018, according to the company's prospectus.
In the prospectus, Syngenta said that its commitment is not only to the transformation and upgrading of global and Chinese agriculture, but also the integration of the world's leading scientific research concepts, technologies and resources with the needs of hundreds of millions of Chinese farmers, and agriculture and rural development.